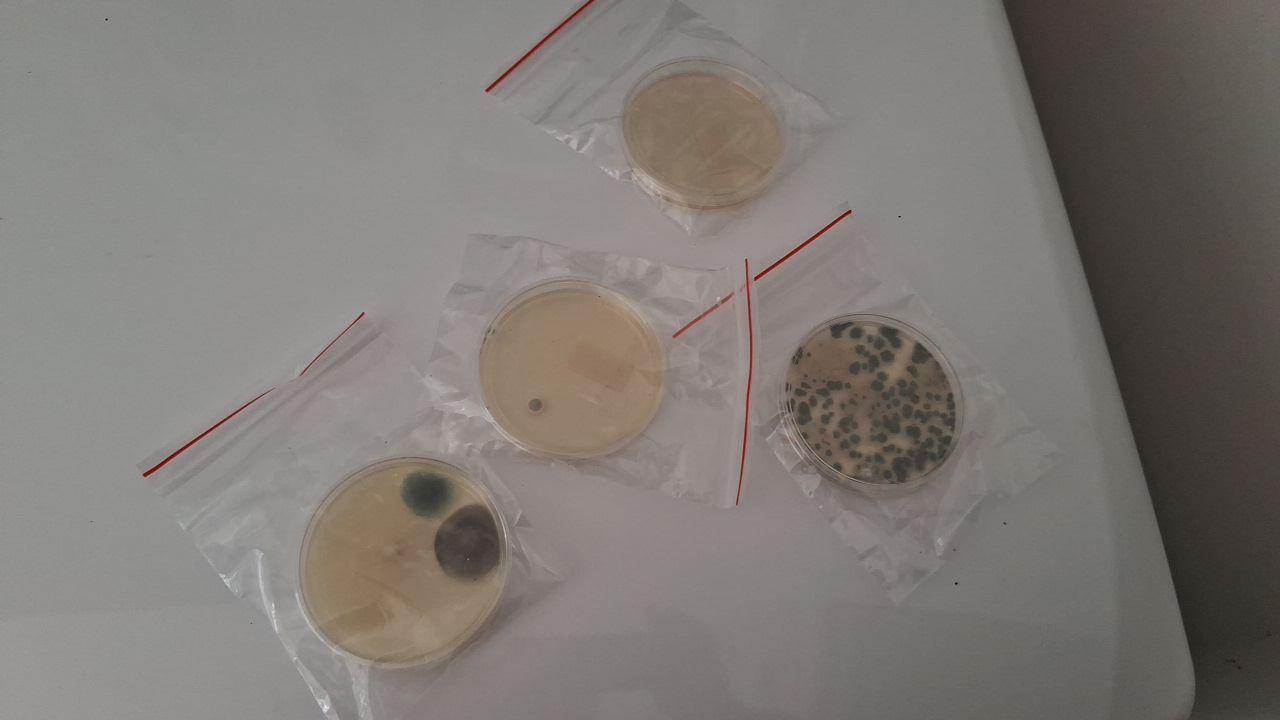

Background
STOP Restoration Charlotte North was recently contacted by a local family concerned about lingering microbial growth following a water intrusion in their upstairs laundry room. Unfortunately, the initial mitigation had been performed by another contractor, not by STOP. The original service was presumed complete – but not long after, the homeowner began to suspect that something had been missed.
Those concerns became urgent when the homeowner’s mother-in-law, who is highly sensitive to mold exposure, began experiencing symptoms that raised red flags. Hoping to confirm their suspicions, the family used a home mold testing kit, which returned positive results for microbial activity in the area.
At that point, the homeowner called STOP Restoration Charlotte North for a professional inspection and remediation plan.
The Challenge
Our inspection revealed what the family feared: visible microbial growth in the exact area where the original water intrusion had occurred. It was clear that the previous contractor had either failed to fully dry the affected materials or missed active microbial colonies during their remediation process.
Because microbial growth can spread quickly – and because a high-risk individual was living in the home – our team needed to act fast, without compromising safety, documentation, or standards.
Our Approach
We immediately established full containment to isolate the affected space from the rest of the home. From there, we:
- Created negative air pressure to prevent any cross-contamination
- Followed all IICRC-certified remediation protocols to remove the microbial contaminatio
- Treated affected materials and ensured moisture readings were within acceptable ranges.
- Completed all work in just two days, minimizing disruption for the family while ensuring thorough remediation
Throughout the process, we documented each step, ensuring transparency for the homeowner and accountability for our team.
Outcome
The result was a fully remediated space, peace of mind for the family, and most importantly, a safe indoor environment for the homeowner and their mother-in-law. The homeowner expressed their appreciation for the difference in professionalism and clarity between STOP Restoration and the previous contractor.
They shared the following Google review after the job:
"The STOP team was a pleasure to work with! Before contracting them, we had mold remediation done by a company that did a poor job and left active mold colonies behind. Needing a more through and complete process, I contacted John and the STOP team came over same day for an inspection, and later in the week to perform the remediation. Everything was very official, thorough and well documented, and each person that came by was professional and a good communicator (the previous company had several workers that did not speak English, which inhibited our ability to ask questions). I wouldn't hesitate to recommend them for any mold mitigation or water damage needs!"
– Graham B.
Conclusion
This case underscores a crucial truth in the restoration industry: when water damage isn't handled properly the first time, it often leads to further damage, health risks, and added costs. Choosing an IICRC-certified company like STOP Restoration Charlotte North ensures that the work is done right – professionally, completely, and with your family’s safety as the top priority.